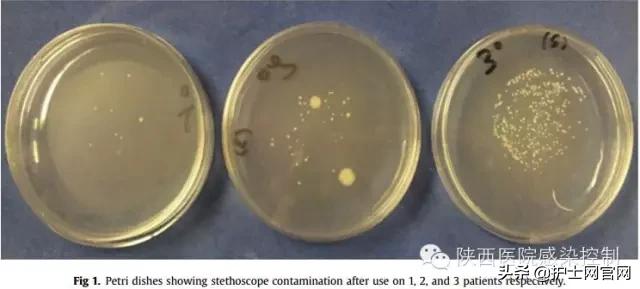
护士长，你们科室的听诊器膜消毒了吗？
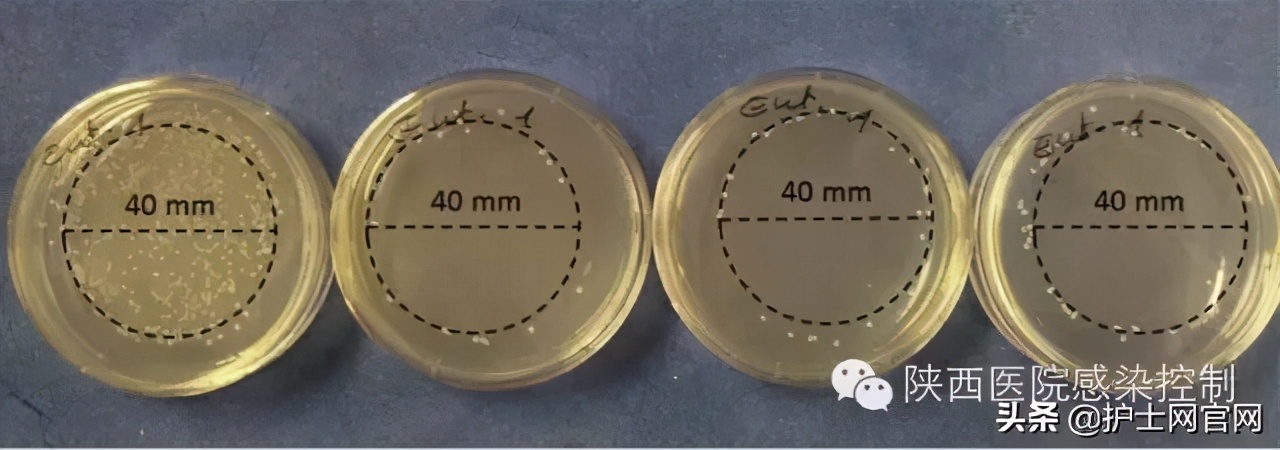
护士长，你们科室的听诊器膜消毒了吗？

导读:
大量文献已经证明控制医院感染的重要性,以及由于院内感染的发生的严重后果,包括造成患者健康受损,死亡率升高,住院时间延长和医疗费用的增加。
据相关meta分析报告在不同的国家和地区由于院内感染造成每例医疗费用的额外增加在2000-15000美元之间。
医务人员的手可以传播病毒和细菌,所有在医务人员和患者之间共同接触的物体都可能成为病原菌传播的媒介。
而听诊器是医务人员最为常用的医疗器械,文献已证明听诊器膜可以将病原菌通过医务人员从一个患者传递给另一个病人。
有研究者在患者的皮肤和其使用过的听诊器膜上分离出同样的铜绿假单胞菌,而在另一研究中,研究者发现在同一ICU病房中两位相同血流感染的患者血培养为同源肺炎克伯菌,而听诊器膜经采样培养也发现相同菌株。听诊器膜是一个重要的交叉感染媒介,听诊器膜上的病原菌可以通过接触传递给其他患者。相关研究表明80%-100%的使用中的听诊器膜上定植有病原菌,如金葡菌(超过85%),20%-40%为MRSA;粪肠球菌(8%);肠杆菌科(6%)。

因此,听诊器膜是传播病原菌的主要途径之一,解决这一问题就是在使用听诊器之前对其进行擦拭消毒,但是可以说在临床工作中由于各种原因很难做到对听诊器膜的消毒处理。而近期的相关文献对于听诊器膜所造成的院内感染发生也给予了很大的关注。
使用紫外线消毒
为了有效的解决这一问题,意大利学者利用紫外线灯对听诊器膜进行处理,研究者在28个听诊器膜上分离出金葡菌、大肠埃希菌、铜绿假单胞菌和粪肠球菌,经过用紫外线灯照射后细菌菌落数明显下降(P〈0.01)其中粪肠球菌下降85.5%,金葡菌减少87.5%,大肠埃希菌减少94.3%,铜绿假单胞菌减少94.9%。
图1:听诊器分别使用1,2,3人后膜表面污染情况
图2:经LED紫外线处理后菌落数明显减少
使用手消
有医疗机构使用水剂的手消毒剂对听诊器进行消毒,让医生在查完一位患者进行手卫生的时候顺便将听诊器也进行消毒。水剂的消毒剂乙醇含量为75%左右,可以杀灭肠道致病菌、化脓性球菌、致病性酵母菌及医院常见感染菌,此方法在临床科室推广的同时感控办也对听诊器进行了消毒前后的对比采样。本次一共进行了五个听诊器的消毒前后对比采样样,结果显示消毒前的听诊器只有一个合格,消毒前合格率为20%,消毒后的听诊器均合格,消毒后合格率为100%。

其他消毒剂
尽管使用乙醇擦拭听诊器膜可以减少病原菌的量,但是随着乙醇的蒸发和听诊器的使用,很快又被污染。洗必泰和三氯生也可用于擦拭消毒,近日国外学者对比了这三种消毒液对于听诊器膜的消毒效果。结果发现洗必泰擦拭消毒后的抑菌效果以可至少持续4小时,细菌残余量明显低于三氯生组和乙醇组。通过对比,研究人员认为对于听诊器膜的清洁消毒推荐使用洗必泰进行擦拭消毒以抑制细菌生长以达到避免交叉感染发生的目的。
根据美国CDC的相关指南,听诊器每次使用时都应该清洁,或如果有明显污染时应该清洁听诊器膜,但是遵循此指南对听诊器膜进行清洁的依从性不到30%(中国不知道有没有3%,关注情况不明)。因此听诊器膜必须进行清洁消毒,以避免交叉感染的发生。
听诊器膜上的细菌量同使用者指腹上的细菌量正相关,而使用者的手卫生依从性又与其指腹上的细菌量负相关,特别是发展中国家的医务人员手卫生依从性较差,其指腹上的细菌载量可想而知。而他们对于听诊器膜的清洁依从性也较低;在这些因素的作用下,听诊器膜所造成的交叉感染必然不低。有推荐使用一次性使用的听诊器膜,但显然无论从可行性和经济性上来看都不适用。
目前国内对于听诊器膜的清洁消毒方式也不尽相同(循证依据不支持酒精擦拭消毒),但无疑本研究给国内医疗机构提供循证参考,同样对于国内医疗消毒生产企业提供资讯,对于听诊器膜的消毒建议使用洗必泰擦拭消毒,相关产品目前未看到。
综上,目前来看紫外线灯照射应该是一个比较好的选择,大家可以将本科室的听诊器集中起来,统一使用紫外线灯照射消毒。